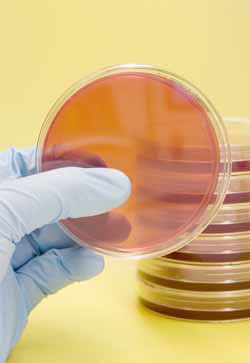
petri dishes

Life as we don't know it
[ http://aca.mq.edu.au/PaulDavies/pdavies.html ] Paul Davies started his career as a theoretical physicist and cosmologist, branching out into science popularisation with successful books, TV series and newspaper articles. Recently he has started to work in astrobiology, a new field that seeks to answer the biggest questions: What is life? Does it exist on other planets? And, if
so, what form might it take?
Tradition has it that the secret of life lies within the chemistry of the "stuff" it is made of, but Davies believes that what really defines it is the fact that it can replicate and process information. The question about the origin of life becomes one about information, how it can be copied and transmitted and the complexity it can generate. Once the search for the essence of life has been
separated from matter, it moves into the realm of physics and mathematics.
What is astrobiology?

Mars seen from space. (Image courtesy of NASA)
NASA defines astrobiology as the study of the origin, distribution, evolution and destiny of life wherever it's found in the universe, not excluding the Earth. You'll notice that, whatever planetary mission NASA embarks on, they always present it as the search for life. Life in space sells; it's popular with the public, and most people are interested in the space exploration programme because of the possibility that we might find life beyond Earth. The subject of astrobiology was invented to capitalise on that interest.
NASA has created a virtual institute called the NASA Astrobiology Institute. Most of their astrobiology is carried out in Ames, a laboratory south of San Francisco. Otherwise it's a network of universities, with just two overseas institutions, one of which is mine - the Australian Centre for Astrobiology.
The current popularity of the subject is all due to Bill Clinton, really. A meteorite from Mars was found in Antarctica in the 1980s, and it had a few little microfeatures that a few NASA scientists thought might be microfossils. They are very small - about a tenth of the size of normal Earth bacteria. This was the rock that made Bill Clinton famous: in 1995 he stood on the White House lawn and talked about the evidence for life on Mars. The jury is still out, but the feeling after 10 years of intensive investigation is that these little features are not microfossils.
What do astrobiologists do?
One of the things astrobiologists are interested in is trying to understand the formation of organic molecules in space, in interstellar clouds and meteorites. There are some quite complex molecules in space, including amino acids, which are what proteins are made of. However, there's still a huge gulf between the stuff out there and life.
Another is trying to understand the origins of life on Earth. The oldest traces of life on Earth are actually in the Pilbara region of Western Australia. My centre has a continuing exploration programme there; students out toiling in the heat looking for microfossils in these rocks, which are 3.5 billion years old.

The Martian landscape - no point in wandering aimlessly. (Image courtesy of NASA)
The Pilbara region is also interesting to us because it's a good Mars analogue. There's no point just aimlessly collecting rocks from Mars to see if they have fossils in - you need to know where to go and what sort of rocks to look at. The belief is that early life lived deep underground or deep in the ocean, in volcanic hot springs. Around the edge of these vents you get microbes that make a living turning dissolved gases into biomass - they don't need light or organic material. When you sequence the genomes of these hot, deep bugs, and you position them on the tree of life, they are the least evolved of all the things on Earth, probably living the same life as they were 3.5 billion years ago. Our people are looking at what evidence would you find on Mars: can you detect the sort of rocks that have been altered by these hydrothermal processes and home in on those and bring those back?
Another area of interest to biologists is the study of "extremophiles" - creatures that are happy living in extreme conditions. There are organisms that live in temperatures up to 121oC; there are others that can live in extreme acid conditions, or extreme radiation, or extreme salt and so on. They are trying to find out what are the outer limits of life: Mars is a hostile environment, but is it that hostile?
My own background is as a physicist and cosmologist, and my interest is in how life begins; where physics stops and biology starts. To a physicist, life seems totally bizarre: the living state of matter is like no other state we ever encounter.
The origins of life as we know it

Potential for cross-contamination? (Painting of a large asteroid impact on Earth, by Donald E. Davis; image courtesy of NASA)
In 1983 Martin Rees organised a meeting in Cambridge called "From matter to life" and I can trace my interest in this subject to that meeting. Then in 1990 I visited Australia and got to know Duncan Steel, who is an expert in anything that hits the earth - asteroids, meteorites and so on. I learnt from him that some of these impacts are big enough to propel material around the solar system, and I had heard at Martin Rees's meeting about the life living deep in rocks, so I thought, well, if you're scattering rocks around, and there's life in the rocks, then can't this life get to Mars and vice versa. I thought surely there's going to be cross-contamination.
My hypothesis is that a comet hits Mars, the Mars rocks get lifted into space, they go into orbit around the sun and maybe after a million years or so one of them hits the Earth. Inside these rocks there will be microbes and it's quite clear that micro-organisms could endure such a journey; they get freeze-dried and are protected from radiation by the rock. And when they find themselves on Earth they will just start up again.
Likewise there may be freeze-dried microbes on Mars at the moment that came from Earth. And 3.5 billion years ago, when there was certainly life on Earth, Mars had lakes and rivers. So it really looks as if Mars is our best bet for finding life elsewhere in the solar system. But the possibility of this cross-contamination does raise the question of whether it would be a genuine second genesis.
What is this thing called life?
What we'd really like to know is whether life is a freak phenomenon that happened just once, or whether it is built into the nature of the universe in a fundamental way. There is nothing in physics that says that matter has got to become living. I think the question has been sidestepped for a hundred years by chemists who think in terms of the "recipe" - that you can make life by mixing a bit of this and a bit of that and stirring.
But from the point of view of the physicist, what's important about life is not the "stuff", it's the information processing. The cell is like a supercomputer, it replicates and processes information, and it seems to me that trying to understand how life emerges means that you have to understand how information processing emerges.
I have a hunch that life started with the replication of quantum information. In quantum information processing, one of the things you want to do is to take a bit of information, a qubit as it's called, and make another that's the same. It doesn't have to be a process for replicating actual molecules.

Life as we know it - the double helix structure of DNA
The way nature does it now, there's a funny-looking molecule - DNA - and a process that replicates that molecule, but there's nothing that says it has to be done that way. The vital thing is to replicate the information. And when you are freed up from the strictures of the "stuff", you don't have to worry about how these molecules would get made - it doesn't matter, because once you start playing the information processing game it could be any system at all. Some scientists are trying to design artificial ways of replicating quantum information; what I'd like to do is find a natural and simple mechanism for taking a quantum bit of information and copying it.
What is the signature of life - what would convince you that something was living? I claim that there is no known example of a system that processes what I call "semantic information" other than life or its products. By semantic information I mean information that means something and is part of a project. A gene, for example, contains a set of very specific instructions, but the information is gobbledegook unless there's a ribosome to interpret it; in other words you need a molecular milieu that has the key to the code and can interpret and act on the information that is stored. Words like "instruction" come to mind: information as a set of instructions rather than a set of meaningless labels that are not part of a coherent scheme.
The key to life
The miracle of Darwinian natural selection is that you can get complex structures from almost nothing, over time - but you've got to start somewhere, and life as we know it is far too complex to have started by accident - unless this happened only once. But if there is a natural route from physics to life, then there's got to be something much simpler than DNA or RNA. And if you look at passing on information rather than physical structures, then it opens up all sorts of new possibilities.
In Chicago in 1952, Harold Urey and his student Stanley Miller decided to try to recreate conditions on early Earth. They put methane, ammonia and carbon dioxide in a flask with some water, sparked some electricity through it, and after a week they got a brown sludge which contained amino acids. Now, making amino acids is a thermodynamically downhill process that will occur automatically - but life as we know it consists of a whole lot of amino acids strung together, and putting them together is thermodynamically uphill.
People thought that because Miller and Urey got amino acids in a week, getting life would just take a bit longer, that it would be just more of same. But it's not more of the same: it's easy to make bricks, but just because you see a pile of bricks doesn't mean that a house is going to form. You've got to assemble them in the right elaborate pattern and that's where the information comes in.
Saying that we form all the molecules that we find in our body from chemistry is as ridiculous as saying that we took all the components of a watch and they all fell in a heap and made a watch and it suddenly started ticking. I'm not arguing for creationism here - what creationists fail to realise is that nobody in their right mind is suggesting that life in all its complexity would form in one great leap. But we do have to find a path from physics and chemistry into life.
So I think the key to life is information - and information is something about which physicists have something to say. Physicists like to look for the underlying principles that make the world tick, and are less concerned with the grubby details. A lot of the chemists and geologists and biologists working in astrobiology are fixated on the details, because the history of life and the Earth is really just a catalogue of historical accidents. But if the mystery is how life got started in the first place, then what you need is to understand the principles at work - and they are things like the second law of thermodynamics, the nature of information processing, the nature of complexity and the rules governing complexity.
A second genesis
If there is indeed a natural way to get from matter to life, are we to suppose that it happened only once on Earth? I see no reason why it shouldn't happen many times. And why go to Mars to look for a second genesis, when there could be multiple geneses right here on our own planet?
The most common form of life here on Earth is microbes - a cubic centimetre of a typical rock contains around a billion microbes. You can't tell what they are just by looking, though. You can try to sequence their genomes - but most of these microbes fail to be sequenced. When you go out to one of these hot springs, and come back with, say, 50 different microbial species, you're lucky if you can culture two or three of them, and of those you are lucky if you can get a genome sequence. The rest you throw down the sink.
Could we grow an unknown form of life in a petri dish?
If we could find a way to filter out known life, then what was left would be life as we don't know it. One idea, which is due to my wife, a radio science journalist, is to look at chirality. Molecules that can't be made to look like their mirror images by rotating or displacing are called chiral - and these include the molecules of life as we know it. [Read more about chirality in Through the looking-glass from issue 24 of Plus.] The amino acids are all left-handed and DNA is right-handed, but there is nothing to say that it couldn't be the other way round - it's just a frozen accident.
But if these alien organisms are in our midst, and they've got the opposite chirality to the molecules in life as we know it, then there's a very simple way of identifying them. We would just make a culture medium with the mirror-image molecules to normal culture medium - "anti-soup" instead of soup - and see what grows. Anything that did grow would be "anti-life".
This experiment is being done right now by NASA at the Marshall Space Flight Center, and we're waiting to hear the results. Of course it's a hell of a long shot, but if we discovered a form of life that was clearly not our life it would be one of the greatest discoveries in the history of science!
Since the time of the interview, the results from the experiment at the Marshall Space Flight Center have come out, but nothing significant was found. Davies is now planning his own experiment in Sydney.
Further reading
You can learn more about quantum information in the Plus articles In a spin and Cracking codes, part II.
About this article

[ http://aca.mq.edu.au/PaulDavies/pdavies.html ]Paul Davies is currently Professor of Natural Philosophy in the Australian Centre for Astrobiology at Macquarie University. His earlier research was in cosmology and theoretical physics. Tongue slightly in cheek, he describes his move into astrobiology as his "mid-life crisis".
Helen Joyce is past editor of Plus. She interviewed Paul Davies in June 2005 when he visited the Centre for Mathematical Sciences in Cambridge.